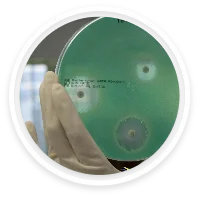
ANÁLISE DE ÁGUA

O Agar Cetrimide (PSA) é um meio de cultura seletivo utilizado para o isolamento e identificação presuntiva de Pseudomonas aeruginosa.
O cetrimide presente no meio inibe o crescimento da maior parte das bactérias contaminantes, favorecendo a recuperação seletiva de P. aeruginosa.
Essa espécie é diferenciada pela produção dos pigmentos característicos:
Piocianina – azul-esverdeado.
Fluoresceína – amarelo-esverdeado sob luz UV.
Composição básica (g/L):
Peptona: 20,0 g
Glicerol: 10,0 g
Cetrimide: 0,3 g
Ágar: 13,6 g
pH final: 7,2 ± 0,2 a 25 °C
Aparência do meio preparado: Levemente amarelado e translúcido.
Condições de incubação: 35–37 °C por 24–48 h.
Finalidade: Seleção de P. aeruginosa e diferenciação pela produção de pigmentos.
O Agar Cetrimide (PSA) é um meio de cultura seletivo utilizado para o isolamento e identificação presuntiva de Pseudomonas aeruginosa.
O cetrimide presente no meio inibe o crescimento da maior parte das bactérias contaminantes, favorecendo a recuperação seletiva de P. aeruginosa.
Essa espécie é diferenciada pela produção dos pigmentos característicos:
Piocianina – azul-esverdeado.
Fluoresceína – amarelo-esverdeado sob luz UV.
Composição básica (g/L):
Peptona: 20,0 g
Glicerol: 10,0 g
Cetrimide: 0,3 g
Ágar: 13,6 g
pH final: 7,2 ± 0,2 a 25 °C
Aparência do meio preparado: Levemente amarelado e translúcido.
Condições de incubação: 35–37 °C por 24–48 h.
Finalidade: Seleção de P. aeruginosa e diferenciação pela produção de pigmentos.
Código do Produto: 4038 – PSA Agar Cetrimide
Apresentações disponíveis:
Pó desidratado: 500 g e 1 kg.
Placas prontas para uso: 90 mm.
Armazenamento: 2–25 °C em local seco e protegido da luz.
Cabine de segurança biológica para manipulação asséptica.
Incubadoras bacteriológicas (35–37 °C).
Lâmpada de luz ultravioleta para detecção de fluoresceína.
Sistema de filtração por membrana (ISO/USP) para análise de água, cosméticos e fármacos.
LIMS (Laboratory Information Management System): para rastreabilidade e registro digital dos resultados.
Sistemas de análise de imagens: identificação e diferenciação de colônias pigmentadas.
Plataformas de monitoramento remoto: acompanhamento de incubação em tempo real.
WhatsApp us